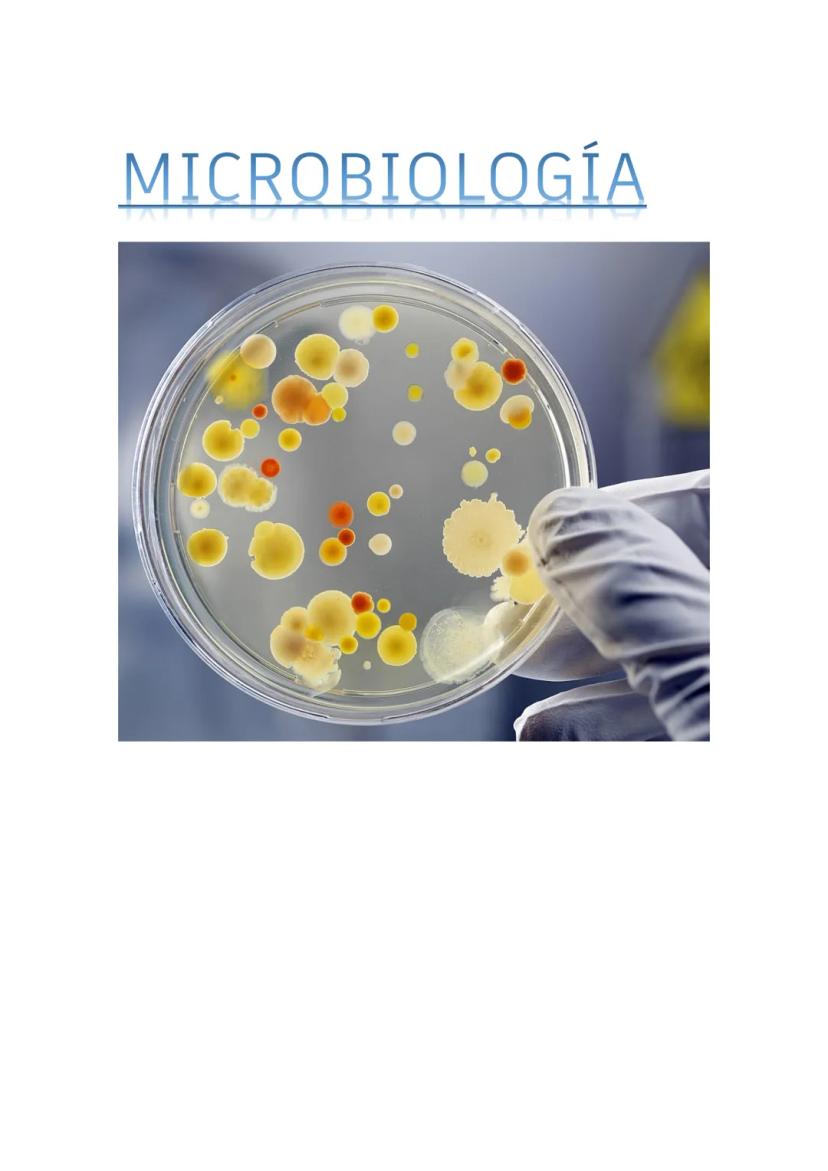

-cultivo de microorganismos segun su medio y finalidad -aislamiento de microorganismo -biorremediacion -fermentaciones y sus aplicaciones
Inscríbete para ver los apuntes¡Es gratis!
Acceso a todos los documentos
Mejora tus notas
Únete a millones de estudiantes
Al registrarte aceptas las Condiciones del servicio y la Política de privacidad.